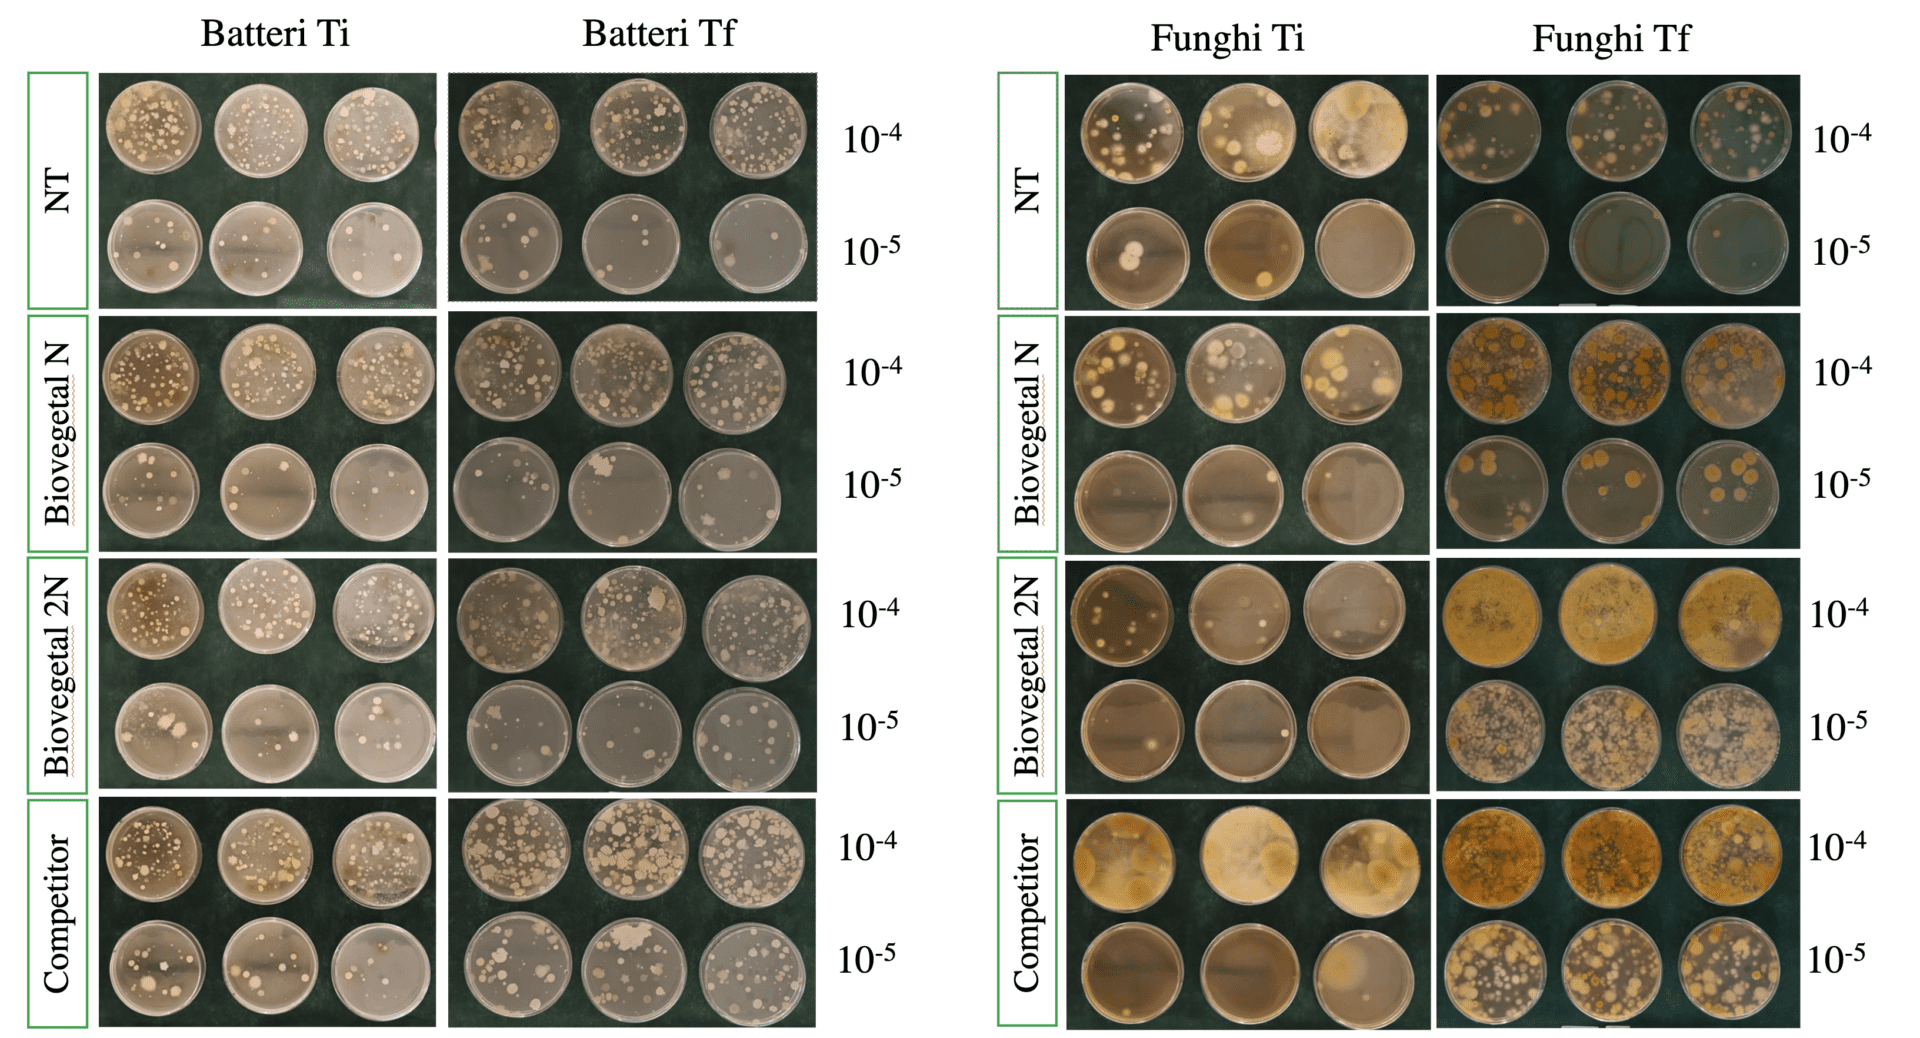
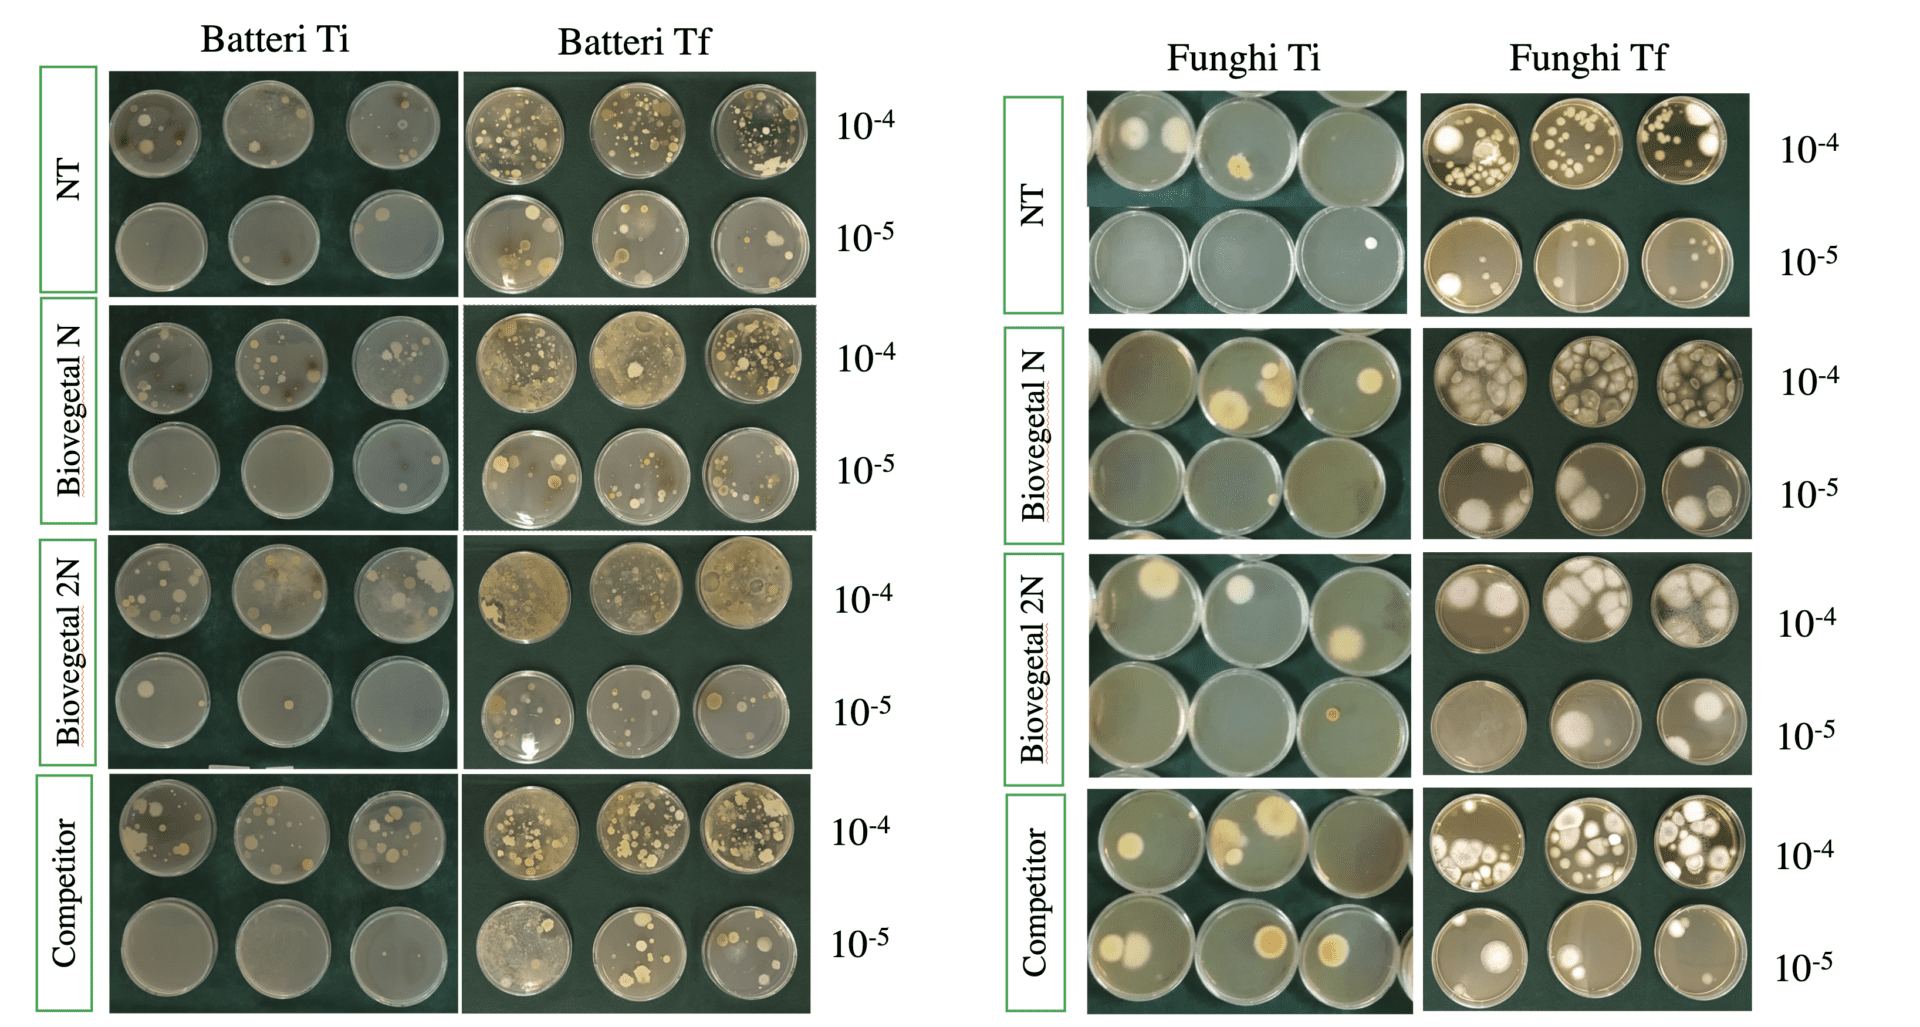

La Sicilia è tra le regioni italiane con la più alta produzione di pomodoro in ambiente protetto. Tuttavia, le piante di pomodoro sono spesso attaccate da diversi fitopatogeni tellurici, tra cui i nematodi, parassiti vegetali presenti nel suolo, capaci di infettare quasi tutte le specie di piante vascolari.
In agricoltura convenzionale, i nematodi vengono controllati tramite l’applicazione di nematocidi, prodotti chimici (alcuni ritirati dal mercato come il bromuro di metile, altri utilizzati in deroga, come il D-D SOIL) che riducono il danno prodotto dai nematodi ma che sono rischiosi per l’ambiente e la salute umana. Esistono, tuttavia, alternative più ecologiche per combattere i nematodi, come l’utilizzo di biofertilizzanti, che migliora la struttura e le proprietà chimico-fisiche-microbiologiche del suolo, crea un ambiente sfavorevole ai nematodi e rende le piante più resistenti agli attacchi parassitari.
Per contrastare i nematodi in maniera naturale, nel 2023 è nata una collaborazione tra Staphyt e l’azienda Tersan Puglia, produttrice di un biofertilizzante chiamato Bio Vegetal.
Si tratta di un mezzo tecnico a base naturale che coniuga una sostanza organica altamente umificata a un consorzio microbico selezionato (composto da funghi e batteri della rizosfera), capace di contrastare i principali fitopatogeni e fitofagi tellurici, compresi i nematodi galligeni. Obiettivo della sperimentazione è stato quello di valutare l’efficacia del Bio Vegetal, sia sulla qualità e quantità del pomodoro sia nel controllo dei nematodi rispetto a un competitor innesco della Disinfezione Anaerobica del Suolo (DAS).
La sperimentazione è stata realizzata in due siti sperimentali:
- Pachino, provincia di Siracusa
- Vittoria, provincia di Siracusa
Le prove sperimentali sono state testate su due varietà di pomodoro (Solanum lycopersicum):
- SV1201TC (Pachino) – datterino
- RIVALDO F1 (Vittoria) – grappolo
Inoltre, lo studio è stato condotto su suoli infestati dal nematode galligeno, Meloidogine incognita.
Durante la prova è stata eseguita un’unica applicazione con trattamenti diversi (Figura 1), i cui dosaggi sono descritti in tabella 1.

Figura 1: foto dei trattamenti utilizzati (sx: Bio Vegetal; dx: competitor)

Tabella 1: dosaggi utilizzati
L’applicazione dei trattamenti è stata eseguita prima della solarizzazione del terreno, circa 60 giorni prima del trapianto (sia a Pachino, che a Vittoria).
Prima del trapianto è stata effettuata una valutazione preliminare della presenza di Meloidogine incognita in un campione di terreno. L’analisi è stata eseguita direttamente nei laboratori di Tersan Puglia, utilizzando la metodica di Cobb, e ha confermato la presenza dei nematodi nel suolo (Tabella 2).

Tabella 2: conta dei nematodi
Durante il periodo di solarizzazione, è stata misurata e registrata per tre volte la temperatura del suolo (Figura 2) in ciascun appezzamento (a Pachino e a Vittoria).

Figura 2: temperatura suolo
Come mostrato in figura 2, le temperature misurate durante la solarizzazione del suolo hanno mostrato leggere differenze tra i trattamenti testati, in entrambi i siti sperimentali.
In seguito ai trattamenti, la sperimentazione ha previsto un’analisi visiva dell’attacco dei nematodi alle radici (Figura 3).

Figura 3: foto sito Vittoria (da dx: NT, Biovegetal 2N, Competitor, Biovegetal N) e grafici della stima visiva dell’attacco dei nematodi alle radici.

Alla fine della raccolta, sia a Pachino che a Vittoria, i risultati relativi all’attacco dei nematodi alle radici hanno evidenziato le differenze riportate nella figura 3.
Il laboratorio fitopatologico di Tersan Puglia ha poi eseguito una conta dei nematodi sui suoli di entrambi i siti, sia all’inizio (T0) sia al termine (Tf) della sperimentazione (Figura 4). I trattamenti con Bio Vegetal, per entrambe le dosi usate, hanno determinato una riduzione del numero dei nematodi rispetto agli altri trattamenti.
La raccolta è stata effettuata in 5 epoche e sono stati misurati il peso dei frutti (produzione), il contenuto di zucchero e la sostanza secca.


Figura 4: peso totale dei frutti (foto a dx. Pachino; foto a sx Vittoria) e incremento % del BV 2N rispetto a NT e al competitor.
In entrambi i siti sperimentali, se considerato il raccolto in maniera globale (totale dei frutti raccolti), il Bio Vegetal ha dato la migliore resa (T/ha) rispetto alle altre parcelle (Figura 4).
Considerando il contenuto di zucchero (°Brix) (Figura 5) o la sostanza secca dei frutti raccolti (Figura 6), i risultati non hanno mostrato differenze statisticamente significative tra i trattamenti.

Figura 5: contenuto zuccherino dei frutti

Figura 6: sostanza secca
Nel laboratorio microbiologico di Tersan Puglia, infine, è stata effettuata anche una conta microbica sui suoli di Pachino (Figura 7) e Vittoria (Figura 8) a inizio (T0) e fine (Tf) sperimentazione.
Figura 7: grafici e foto della conta microbica suolo pachino
Figura 8: foto della conta microbica suolo Vittoria
In entrambi i siti sperimentali, a fine sperimentazione, la presenza dei trattamenti, soprattutto del Bio Vegetal, ha consentito di avere una attività microbica più elevata rispetto al controllo non trattato e al competitor (Figure 8 e 9).
In conclusione, in presenza di una media infestazione di nematodi su campi di pomodoro, la somministrazione del Bio Vegetal genera effetti positivi sull’incremento quali-quantitativo della produzione nonché sulla vigoria delle piante, sia rispetto al competitor sia al controllo non trattato. Infatti, i risultati confermano come il trattamento con Bio Vegetal (2N) abbia fatto registrare un aumento della produttività dell’8% rispetto al competitor, senza compromettere gli aspetti qualitativi come, per esempio, i °Brix e il contenuto di sostanza secca.
Un altro aspetto interessante dello studio condotto è che la biofertilizzazione con il Bio Vegetal applicato in pre-solarizzazione ha fatto registrare un aumento delle temperature del suolo rispetto alle altre tesi, migliorando l’efficacia della geodisinfestazione.
Dal punto di vista della fertilità biologica del suolo, è emerso che le tesi trattate con Bio Vegetal (dose N e 2N) hanno fatto registrare un aumento importante dei microrganismi tellurici a seguito del trattamento, con un incremento superiore alle altre tesi poste a confronto. Viceversa, le analisi dei nematodi prima della sperimentazione (T0) e alla fine della sperimentazione (Tf) hanno confermato l’importanza del ruolo della biofertilizzazione nel contenimento biologico dei fitopatogeni tellurici.
Infine, è importante ribadire che l’approccio agronomico della biofertilizzazione è del tutto sostenibile e il comparto orticolo è uno tra i più sensibili al tema della sostenibilità ambientale. Inoltre, recenti studi sulle percezioni dei consumatori hanno dimostrato che produrre e commercializzare ortaggi con caratteristiche di sostenibilità è una strategia promettente per la differenziazione della qualità.
Vieni a conoscere tutti i vantaggi e le potenzialità di Bio Vegetal alla Pomodoro Exhibition 2024, una giornata tecnica in campo programmata per l’11 luglio, alle ore 16.00, presso l’azienda agricola Agroenergie Soc. Agr. Srl di Scoglietti, frazione di Vittoria (RG).
Iscriviti qui: https://forms.gle/ePwX5jU25VFNFLm16
Comunicato a cura di Tersan Puglia
© fruitjournal.com